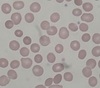

Blood fillms Flashcards
(11 cards)
What conditions might cause the appearance of target cells?

Sickle cell anaemia
Thalassaemia
Iron deficiency anaemia
Hyposplenism
Liver disease
Target cells arise because of the red cell’s surface area increasing disproportionatly to its volume, either because of increased red cell surface area or decreased haemoglobin content
What condition might cause the appearance of ‘tear drop’ poikilocytes (aka dacrocytes)?

Myelofibrosis (myeldodysplastic syndromes, rare forms of acute leukaemias, or myelofibrosis associated with autoimmune conditions, toxins, post-irradiation, inborn haemolytic anaemias, iron deficiency or beta thalassaemia)
What conditions might cause the appearance of spherocytes?
Hereditary spherocytosis
Autoimmune haemolytic anaemia
Spherocytes - sphere-shaped rather than biconcave RBCs. Found in all haemolytic anaemias to some degree, however only the above two are characterised by only having spherocytes)
What conditions might case the appearance of basophilic stippling?

Lead poisoning
Thalassaemia
Sideroblastic anaemia
Myelodysplasia
What condition might cause the appearance of Howell-Jolly bodies?

Hyposplenism (damaged or absent)
Howell-Jolly bodies are erythrocytes that contain a small amount of remnant DNA that would usually be removed from the circulation
What conditions might cause the appearance of Heinz bodies?

G6PD deficiency
Alpha thalassaemia
Heinz bodies are inclusions within red blood cells composed of denatured haemoglobin, and appear usually as a result of oxidative damage to haemoglobin component molecules
What conditions might cause the appearance of schistocytes (‘helmet cells’)?

Intravascular haemolysis
Mechanical heart valves
DIC
Schistocytes are created by trying to move past areas of intravascular blockage, with red cells becoming damaged by fibrin strands created by the above conditions. Think “putting on a helmet to protect yourself from damage!”
What condition might cause the appearance of pencil poikilocytes?

Iron deficiency anaemia
What conditions might cause the appearance of Burr cells (echinocytes)?

Uraemia
Pyruvate kinase deficiency
What condition might cause the appearance of hypersegmented neutrophils?
Megaloblastic anaemia
What condition might cause the appearance of bite cells (“degmacytes”)?
G6PD deficiency
Bite cells result from denatured haemoglobin being removed by macrophages in the spleen